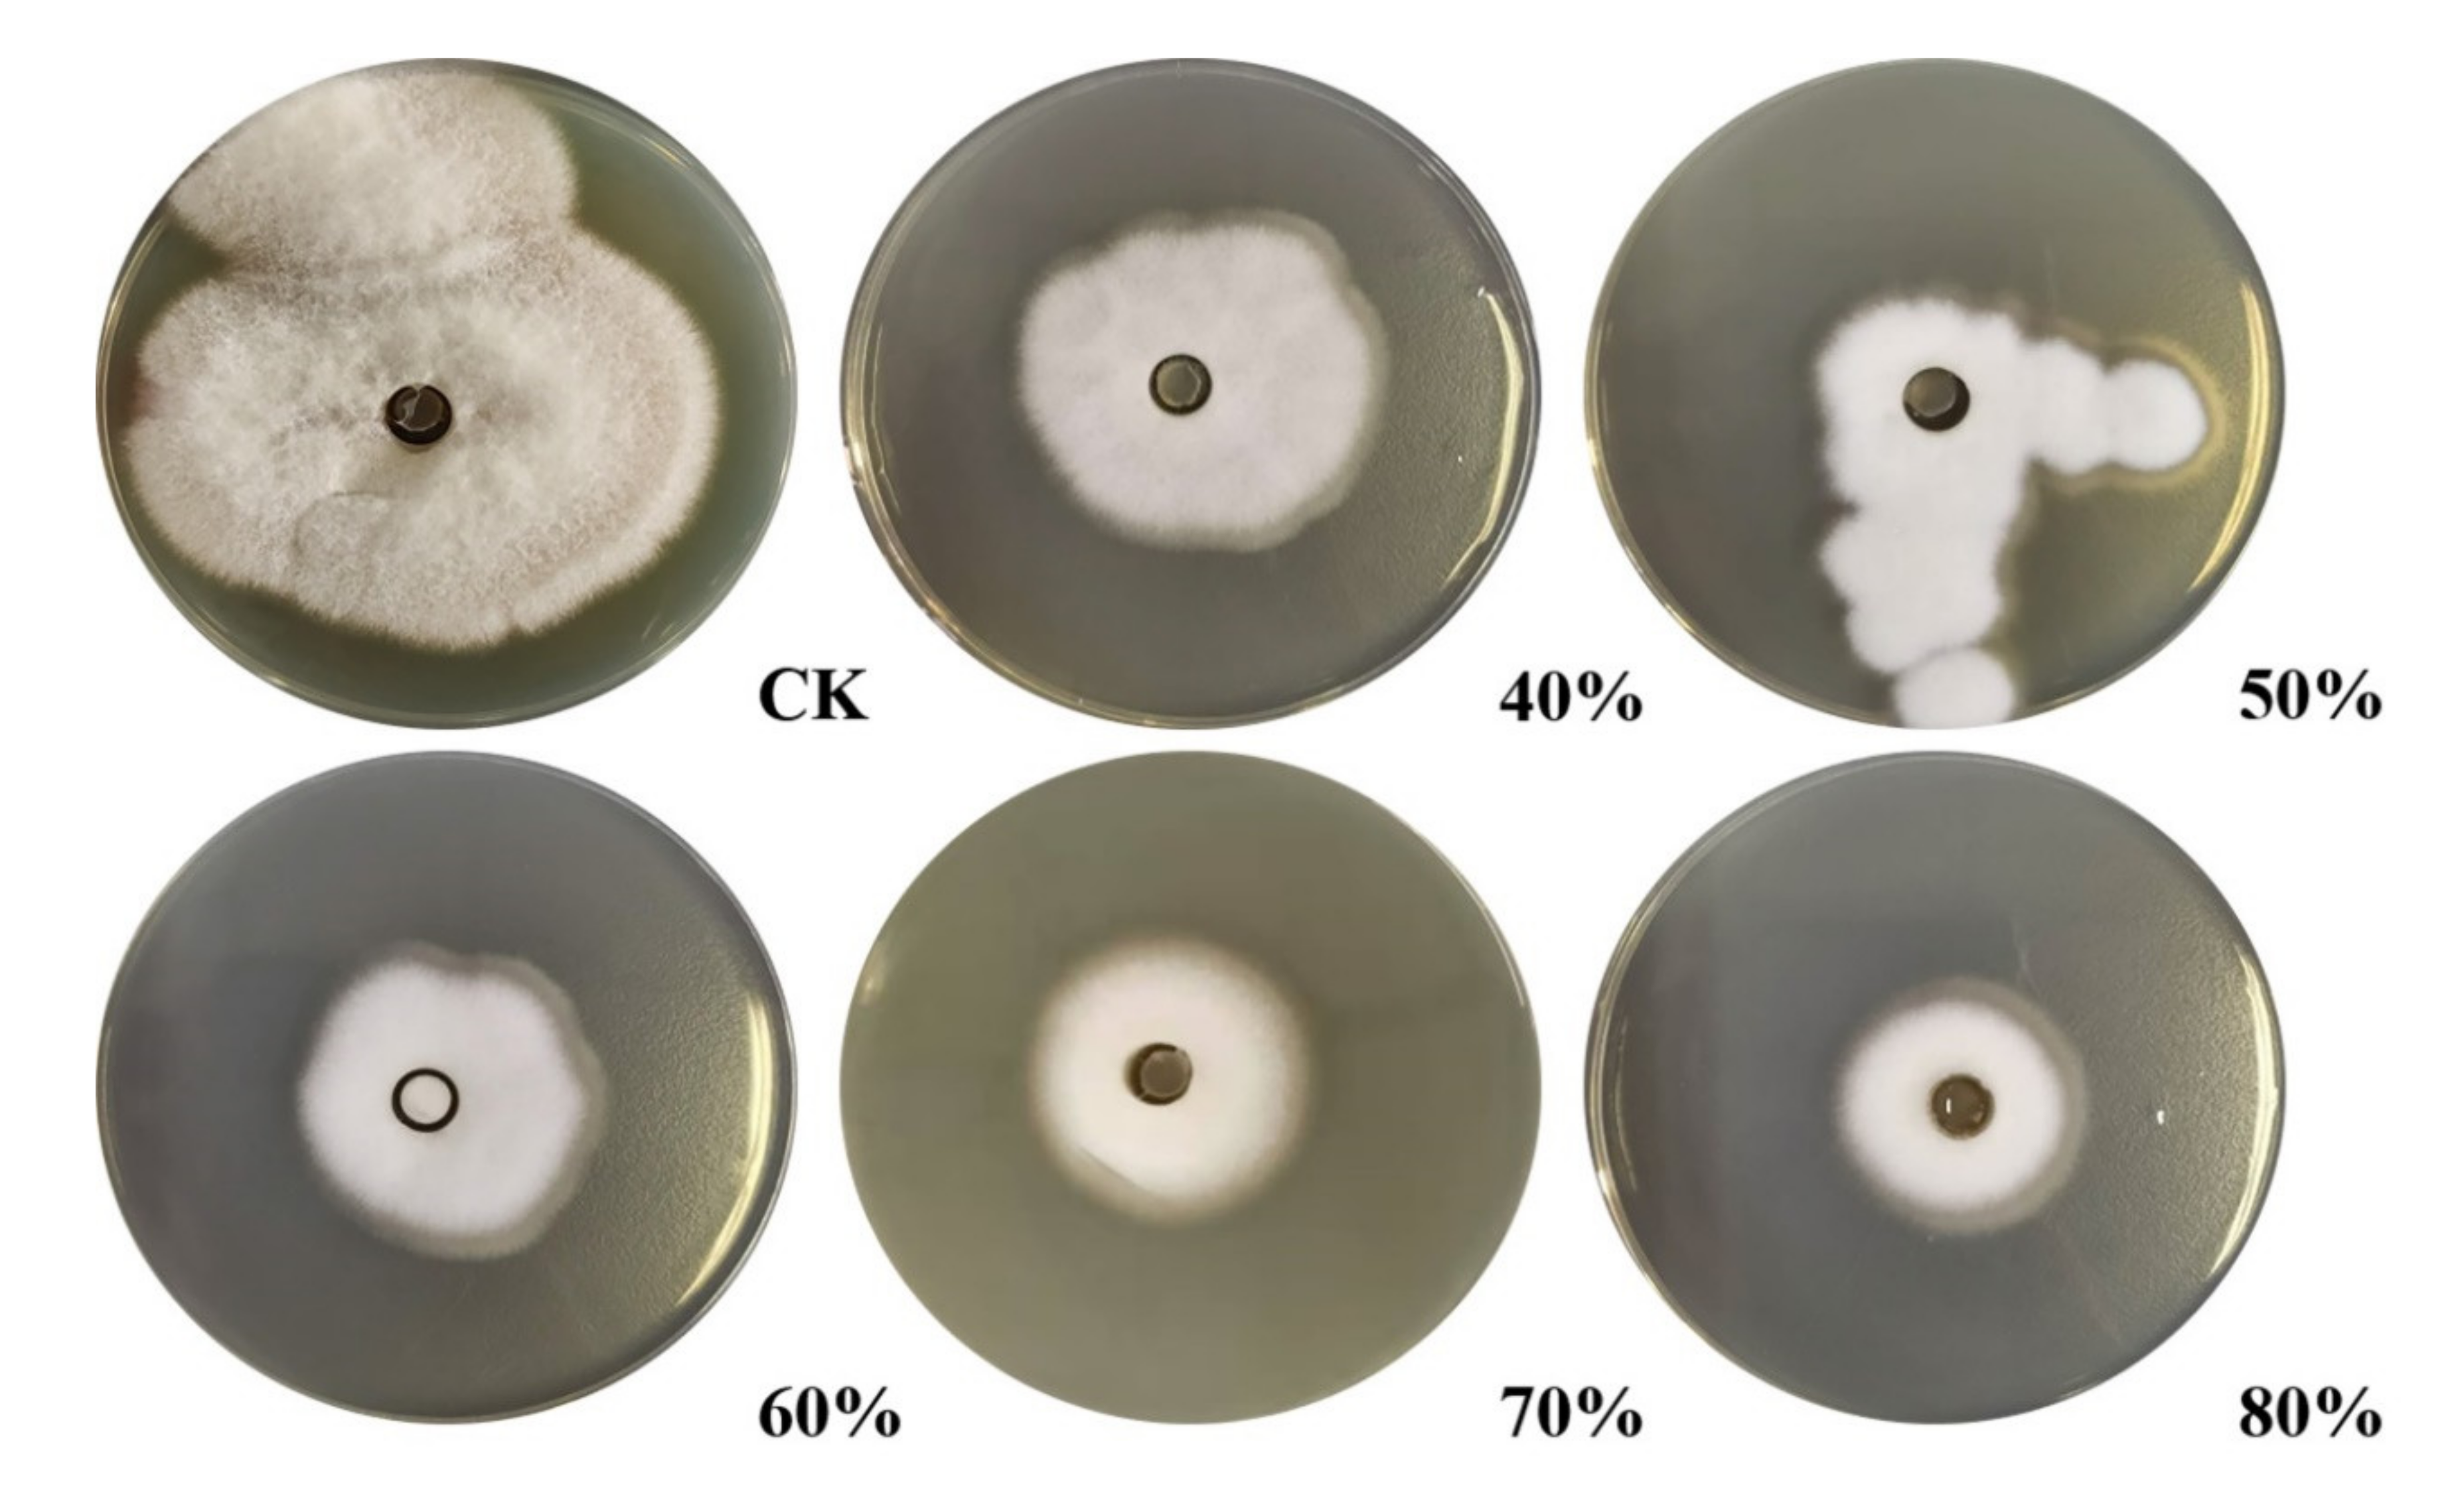
Molecules 26 01863 g001

An Antifungal Chitosanase from Bacillus subtilis SH21
Abstract
1. Introduction
2. Results
2.1. Identification of Bacillus SH21
2.2. Purification of the Antifungal Protein from B. subtilis SH21
2.3. Assessment of the Protein Purity
2.4. Characterization of the Protein via LC–MS/MS Analysis
2.5. Assessment of the Minimum Inhibitory Concentration of Chitosanase SH21 Against F. solani
2.6. SEM and TEM Assessment of the Effect of Chitosanase SH21 on F. solani
2.7. Sequence, Structure Analysis, and Modeling
3. Discussion
4. Materials and Methods
4.1. Microorganisms, Culture Conditions, and Reagents
4.2. Strain Identification
4.3. Purification of the Antifungal Protein
4.4. Determination of the Purity
4.5. Determination of the Molecular Weight and Amino Acid Sequence
4.6. Assessment of the Antifungal Activity
4.7. The Minimum Inhibitory Concentration (MIC) of the Chitosanase SH21 Against F. solani
4.8. Electron Microscopy
4.9. Cloning of Chitosanase Gene, Sequence Analysis, and Homology Modeling
4.10. Statistical Analyses
5. Conclusions
Author Contributions
Funding
Acknowledgments
Conflicts of Interest
Sample Availability
References
- Rojo, F.G.; Reynoso, M.M.; Ferez, M.; Chulze, S.N.; Torres, A.M. Biological control by Trichoderma species of Fusarium solani causing peanut brown root rot under field conditions. Crop. Prot. 2007, 26, 549–555. [Google Scholar] [CrossRef]
- Ahmad, Z.; Wu, J.; Chen, L.; Dong, W. Isolated Bacillus subtilis strain 330-2 and its antagonistic genes identified by the removing PCR. Sci. Rep. 2017, 7, 1–13. [Google Scholar] [CrossRef]
- Tan, T.; Zhu, J.; Shen, A.; Li, J.; Yu, Y.; Zhang, M.; Zhao, M.; Li, Z.; Chen, J.; Gao, C.; et al. Isolation and identification of a Bacillus subtilis HZ-72 exhibiting biocontrol activity against flax seedling blight. Eur. J. Plant Pathol. 2019, 153, 825–836. [Google Scholar] [CrossRef]
- Zhang, B.; Wang, J.; Xiangning, C.; Yuan, Q.; Chen, X.; Zhang, Y.; Fan, J. Peptides derived from tryptic hydrolysate of Bacillus subtilis culture suppress fungal spoilage of table grapes. Food Chem. 2018, 239, 520–528. [Google Scholar] [CrossRef]
- Wang, N.N.; Yan, X.; Gao, X.N.; Niu, H.J.; Kang, Z.S.; Huang, L.L. Purification and characterization of a potential anti-fungal protein from Bacillus subtilis E1R-J against Valsa mali. World J. Microbiol. Biotechnol. 2016, 32, 63. [Google Scholar] [CrossRef] [PubMed]
- Ren, J.; He, W.; Li, C.; He, S.; Niu, D. Purification and identification of a novel antifungal protein from Bacillus subtilis XB-1. World J. Microbiol. Biotechnol. 2019, 35, 150. [Google Scholar] [CrossRef] [PubMed]
- Mu, J.; Li, X.; Jiao, J.; Ji, G.; Wu, J.; Hu, F.; Li, H. Biocontrol potential of vermicompost through antifungal volatiles produced by indigenous bacteria. Biol. Control. 2017, 112, 49–54. [Google Scholar] [CrossRef]
- Fan, H.; Ru, J.; Zhang, Y.; Wang, Q.; Li, Y. Fengycin produced by Bacillus subtilis 9407 plays a major role in the biocontrol of apple ring rot disease. Microbiol. Res. 2017, 199, 89–97. [Google Scholar] [CrossRef] [PubMed]
- Kim, P.I.; Ryu, J.; Kim, Y.H.; Chi, Y.-T. Production of Biosurfactant Lipopeptides Iturin A, Fengycin and Surfactin A from Bacillus subtilis CMB32 for Control of Colletotrichum gloeosporioides. J. Microbiol. Biotechnol. 2010, 20, 138–145. [Google Scholar] [CrossRef]
- Yang, L.-Y.; Zhang, J.-L.; Bassett, C.L.; Meng, X.-H. Difference between chitosan and oligochitosan in growth of Monilinia fructicola and control of brown rot in peach fruit. LWT 2012, 46, 254–259. [Google Scholar] [CrossRef]
- Pechsrichuang, P.; Lorentzen, S.B.; Aam, B.B.; Tuveng, T.R.; Hamre, A.G.; Eijsink, V.G.; Yamabhai, M. Bioconversion of chitosan into chito-oligosaccharides (CHOS) using family 46 chitosanase from Bacillus subtilis (BsCsn46A). Carbohydr. Polym. 2018, 186, 420–428. [Google Scholar] [CrossRef]
- Seki, K.; Nishiyama, Y.; Mitsutomi, M. Characterization of a novel exo-chitosanase, an exo-chitobiohydrolase, from Gongronella butleri. J. Biosci. Bioeng. 2019, 127, 425–429. [Google Scholar] [CrossRef]
- Zhang, H.; Sang, Q.; Zhang, W. Statistical optimization of chitosanase production by Aspergillus sp. QD-2 in submerged fermentation. Ann. Microbiol. 2011, 62, 193–201. [Google Scholar] [CrossRef]
- Da Silva, L.C.A.; Honorato, T.L.; Franco, T.T.; Rodrigues, S. Optimization of Chitosanase Production by Trichoderma koningii sp. Under Solid-State Fermentation. Food Bioprocess Technol. 2010, 5, 1564–1572. [Google Scholar] [CrossRef]
- Yang, Y.; Zheng, Z.; Xiao, Y.; Zhang, J.; Zhou, Y.; Li, X.; Li, S.; Yu, H. Cloning and Characterization of a Cold-adapted Chitosanase from Marine Bacterium Bacillus sp. BY01. Molecules 2019, 24, 3915. [Google Scholar] [CrossRef]
- Qin, Z.; Luo, S.; Li, Y.; Chen, Q.; Qiu, Y.; Zhao, L.; Jiang, L.; Zhou, J. Biochemical properties of a novel chitosanase from Bacillus amyloliquefaciens and its use in membrane reactor. LWT 2018, 97, 9–16. [Google Scholar] [CrossRef]
- Doan, C.T.; Tran, T.N.; Nguyen, V.B.; Nguyen, A.D.; Wang, S.-L. Production of a Thermostable Chitosanase from Shrimp Heads via Paenibacillus mucilaginosus TKU032 Conversion and its Application in the Preparation of Bioactive Chitosan Oligosaccharides. Mar. Drugs 2019, 17, 217. [Google Scholar] [CrossRef]
- Patantis, G.; Zilda, D.S.; Fawzya, Y.N.; Chasanah, E. Purification of chitosanase from Stenotrophomonas maltophilia KPU 2123 and Micromonospora sp. T5a1 for chitooligosacharide production. Earth Environ. Sci. 2019, 404, 012078. [Google Scholar] [CrossRef]
- Thadathil, N.; Velappan, S.P. Recent developments in chitosanase research and its biotechnological applications: A review. Food Chem. 2014, 150, 392–399. [Google Scholar] [CrossRef]
- Qin, Z.; Chen, Q.; Lin, S.; Luo, S.; Qiu, Y.; Zhao, L. Expression and characterization of a novel cold-adapted chitosanase suitable for chitooligosaccharides controllable preparation. Food Chem. 2018, 253, 139–147. [Google Scholar] [CrossRef]
- Han, Y.; Gao, P.; Yu, W.; Lu, X. N-Terminal seven-amino-acid extension simultaneously improves the pH stability, optimal temperature, thermostability and catalytic efficiency of chitosanase CsnA. Biotechnol. Lett. 2017, 40, 75–82. [Google Scholar] [CrossRef]
- Schoffelmeer, E.; Klis, F.; Sietsma, J.; Cornelissen, B. The Cell Wall of Fusarium oxysporum. Fungal Genet. Biol. 1999, 27, 275–282. [Google Scholar] [CrossRef] [PubMed]
- Fukamizo, T.; Ohkawa, T.; Sonoda, K.; Toyoda, H.; Nishiguchi, T.; Ouchi, S.; Goto, S. Chitinous Components of the Cell Wall of Fusarium oxysporum. Biosci. Biotechnol. Biochem. 1992, 56, 1632–1636. [Google Scholar] [CrossRef]
- Yan, R.; Hou, J.; Ding, D.; Guan, W.; Wang, C.; Wu, Z.; Li, M. In vitro antifungal activity and mechanism of action of chitinase against four plant pathogenic fungi. J. Basic Microbiol. 2008, 48, 293–301. [Google Scholar] [CrossRef] [PubMed]
- Boucher, I.; Fukamizo, T.; Honda, Y.; Willick, G.E.; Neugebauer, W.A.; Brzezinski, R. Site-directed Mutagenesis of Evolutionary Conserved Carboxylic Amino Acids in the Chitosanase from Streptomyces sp. N174 Reveals Two Residues Essential for Catalysis. J. Biol. Chem. 1995, 270, 31077–31082. [Google Scholar] [CrossRef] [PubMed]
- Gao, X.-A.; Ju, W.-T.; Jung, W.-J.; Park, R.-D. Purification and characterization of chitosanase from Bacillus cereus D-11. Carbohydr. Polym. 2008, 72, 513–520. [Google Scholar] [CrossRef]
- Wee, Y.-J.; Reddy, L.V.; Yoon, S.-D.; Ryu, H.-W. Purification and enzymatic properties of the extracellular and constitutive chitosanase produced by Bacillus subtilis RKY3. J. Chem. Technol. Biotechnol. 2011, 86, 757–762. [Google Scholar] [CrossRef]
- Sun, H.; Cao, R.; Li, L.; Zhao, L.; Liu, Q. Cloning, purification and characterization of a novel GH46 family chitosanase, Csn-CAP, from Staphylococcus capitis. Process. Biochem. 2018, 75, 146–151. [Google Scholar] [CrossRef]
- Pechsrichuang, P.; Yoohat, K.; Yamabhai, M. Production of recombinant Bacillus subtilis chitosanase, suitable for biosynthesis of chitosan-oligosaccharides. Bioresour. Technol. 2013, 127, 407–414. [Google Scholar] [CrossRef] [PubMed]
- Su, C.; Wang, D.; Yao, L.; Yu, Z. Purification, Characterization, and Gene Cloning of a Chitosanase from Bacillus Species Strain S65. J. Agric. Food Chem. 2006, 54, 4208–4214. [Google Scholar] [CrossRef]
- Guo, N.; Sun, J.; Wang, W.; Gao, L.; Liu, J.; Liu, Z.; Xue, C.; Mao, X. Cloning, expression and characterization of a novel chitosanase from Streptomyces albolongus ATCC 27414. Food Chem. 2019, 286, 696–702. [Google Scholar] [CrossRef]
- Oh, C.-H.; Zoysa, M.D.; Kang, D.-H.; Lee, Y.-D.; Whang, I.-S.; Nikapitita, C.; Heo, S.-J.; Yoon, K.-T.; Affan, A.; Lee, J.-H. Isolation, Purification, and Enzymatic Characterization of Extracellular Chitosanase from Marine Bacterium Bacillus subtilis CH2. J. Microbiol. Biotechnol. 2011, 21, 1021–1025. [Google Scholar] [CrossRef]
- Gu, T.Y. Biochemical characterization of a glycoside hydrolase family 19 chitinase from Streptomyces alfalae and its applications. Hebei Agric. Univ. 2019, 5. [Google Scholar]
- Song, Y.-S.; Seo, D.-J.; Jung, W.-J. Characterization and antifungal activity of chitosanase produced by Pedobacter sp. PR-M6. Microb. Pathog. 2019, 129, 277–283. [Google Scholar] [CrossRef]
- Zhu, X.-F.; Tan, H.-Q.; Zhu, C.; Liao, L.; Zhang, X.-Q.; Wu, M. Cloning and overexpression of a new chitosanase gene from Penicillium sp. D-1. AMB Express 2012, 2, 13. [Google Scholar] [CrossRef]
- Bradford, M.M. A rapid and sensitive method for the quantitation of microgram quantities of protein utilizing the principle of protein-dye binding. Anal. Biochem. 1976, 72, 248–254. [Google Scholar] [CrossRef]
- Laemmli, U.K. Cleavage of structural proteins during the assembly of the head of bacteriophage T4. Nature 1970, 227, 680–685. [Google Scholar] [CrossRef]
- Jones, P.; Binns, D.; Chang, H.-Y.; Fraser, M.; Li, W.; McAnulla, C.; McWilliam, H.; Maslen, J.; Mitchell, A.; Nuka, G.; et al. InterProScan 5: Genome-scale protein function classification. Bioinformatics 2014, 30, 1236–1240. [Google Scholar] [CrossRef] [PubMed]
- Huang, Y.; Luo, Y.; Zhai, Z.; Zhang, H.; Yang, C.; Tian, H.; Li, Z.; Feng, J.; Liu, H.; Hao, Y. Characterization and application of an anti-Listeria bacteriocin produced by Pediococcus pentosaceus 05-10 isolated from Sichuan Pickle, a traditionally fermented vegetable product from China. Food Control. 2009, 20, 1030–1035. [Google Scholar] [CrossRef]
- Mandal, S.; Mandal, M.D.; Pal, N.K. Reduced minimum inhibitory concentration of chloramphenicol for Salmonella enterica serovar typhi. Indian J. Med. Sci. 2004, 58, 16. [Google Scholar] [PubMed]
- Qingmei, H.; Zhensheng, K.; Lili, H.; Xuanli, J. Cytology and immuno-cytochemistry studies of effects of tebuconazole on wheat head blight pathogen in vitro. Mycosystema 2004, 23, 580–589. [Google Scholar]

| Purification Procedure | Volume (mL) | Total Protein (mg) | Yield (%) |
|---|---|---|---|
| Crude enzyme | 1000 | 260 | 100 |
| (NH4)2SO4 ppt | 15 | 125 | 48.1 |
| Superdex75PG | 25 | 37.5 | 14.4 |
| SP-HPR | 5 | 3 | 1.2 |
| Protein IDs | Protein Names | Sequence Coverage (%) | Mol. Weight (kDa) | Score |
|---|---|---|---|---|
| D4FZ80 | Chitosanase | 86.3 | 30.72 | 323.31 |
Publisher’s Note: MDPI stays neutral with regard to jurisdictional claims in published maps and institutional affiliations. |
© 2021 by the authors. Licensee MDPI, Basel, Switzerland. This article is an open access article distributed under the terms and conditions of the Creative Commons Attribution (CC BY) license (http://creativecommons.org/licenses/by/4.0/).
Share and Cite
Pang, Y.; Yang, J.; Chen, X.; Jia, Y.; Li, T.; Jin, J.; Liu, H.; Jiang, L.; Hao, Y.; Zhang, H.; et al. An Antifungal Chitosanase from Bacillus subtilis SH21. Molecules 2021, 26, 1863. https://doi.org/10.3390/molecules26071863
Pang Y, Yang J, Chen X, Jia Y, Li T, Jin J, Liu H, Jiang L, Hao Y, Zhang H, et al. An Antifungal Chitosanase from Bacillus subtilis SH21. Molecules. 2021; 26(7):1863. https://doi.org/10.3390/molecules26071863
Chicago/Turabian StylePang, Yuanxiang, Jianjun Yang, Xinyue Chen, Yu Jia, Tong Li, Junhua Jin, Hui Liu, Linshu Jiang, Yanling Hao, Hongxing Zhang, and et al. 2021. "An Antifungal Chitosanase from Bacillus subtilis SH21" Molecules 26, no. 7: 1863. https://doi.org/10.3390/molecules26071863
APA StylePang, Y., Yang, J., Chen, X., Jia, Y., Li, T., Jin, J., Liu, H., Jiang, L., Hao, Y., Zhang, H., & Xie, Y. (2021). An Antifungal Chitosanase from Bacillus subtilis SH21. Molecules, 26(7), 1863. https://doi.org/10.3390/molecules26071863
